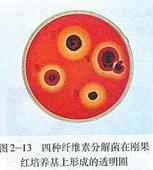
剛果紅染色法

含義
剛果紅染色法特指纖維素的染色法,剛果紅能把纖維素染成紅色複合物,對纖維二糖和葡萄糖無作用,可用此來鑑別纖維素或纖維素分解菌的分解作用
原理
剛果紅染色法
剛果紅染色法剛果紅能與培養基中的纖維素形成紅色複合物。當纖維素被纖維素酶分解後,剛果紅——纖維素的複合物便沒法形成,培養基中會出現以纖維素分解菌為中心的透明圈,通過是否產生透明圈來篩選纖維素分解菌
方法
常用的剛果紅染色法有兩種
方法一,先培養微生物,再加入剛果紅進行顏色反應
在長出菌落的培養基上,覆蓋質量濃度為1 mg/mI。的CR溶液,10~15 min後,倒去CR溶液,加入物質的量濃度為l mol/l的NaCI溶液,15 min後倒掉NaCl溶液,此時,產生纖維素酶的菌落周圍將會出現透明圈。
(加NaCl的原因:剛果紅是結合到培養基的多糖底物,但分解纖維素的細菌可以產纖維素酶,能分解這個多糖底物成為寡糖,這樣剛果紅就不能結合上去了,氯化鈉就可以使結合不牢的剛果紅洗去,這樣就留下大小不一的透明圈,大的透明圈分解纖維素的能力就強)
方法二,在倒平板時就加入剛果紅
配製質量濃度為10 mg/mI的CR溶液,滅菌後,按照每200 mI。培養基加入1 mI。的比例加入CR溶液,混勻後倒平板。等培養基上長出茵落後,產生纖維素酶的菌落周圍將會出現明顯的透明圈
兩種剛果紅染色法的比較 : 剛果紅在篩選纖維素分解菌上的套用已經有超過20年的歷史,課本中給出了兩種方法。
方法一是傳統的方法,
優點:這樣顯示出的顏色反應基本上是纖維素分解菌的作用。
缺點:操作繁瑣,加入剛果紅溶液會使菌落之間發生混雜;
方法二
優點:操作簡便,不存在菌落混雜問題,
缺點1:由於在纖維素粉和瓊脂、土豆汁中都含有澱粉類物質,可以使能夠產生澱粉酶的微生物出現假陽性反應。但這種只產生澱粉酶的微生物產生的透明圈較為模糊,因為培養基中纖維素占主要地位,因此可以與纖維素酶產生的透明圈相區分。
缺點2:有些微生物具有降解色素的能力,它們在長時間培養過程中會降解剛果紅而形成明顯的透明圈,與纖維素分解菌不易區分

